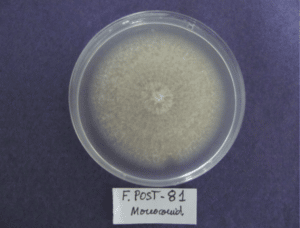
Fusarium solani

España, específicamente la región de Huelva, se posiciona como el principal productor y exportador de frutilla/fresa en la Unión Europea. La superficie plantada se encuentra en más de un 90% con sistemas de cubierta como macro túneles y micro túneles. Se estima que cerca de un 3% también se encuentra fuera de suelo o en hidroponía.
Los diferentes sistemas de cubierta plástica en Huelva. De izquierda a derecha: macro túneles, micro túneles y sistema fuera de suelo
Las plantaciones de frutilla/fresa en Huelva han ido aumentando en los últimos años y una de las características de los establecimientos es que se practica el monocultivo.
A pesar de que la producción de frutilla/fresa en Huelva ha sido altamente dependiente de fumigantes de suelo, las regulaciones internacionales han ido poniendo obstáculo a esta práctica, por lo que el monocultivo puede significar o no una condición potencial para la persistencia de enfermedades en el suelo.
En la última década debido a este escenario, han sido detectadas nuevas especies de hongos patógenos de la frutilla/fresa, entre ellas, Macrophomina phaseolina y Fusarium solani.
Este último agente patógeno provoca una serie de síntomas en las frutillas/fresas, tales como marchitez, enanismo y escasa producción de raíces.
Marchitez ocasionada por Fusarium solani en frutilla/fresa
Enanismo en frutilla/fresa provocado por Fusarium solani
Pobre desarrollo de raíces por ataque del hongo
Corona con necrosis a causa de Fusarium solani
La cada vez más frecuente aparición de estos síntomas alertó a científicos del IFAPA (Instituto de Investigación y Formación Agraria y Pesquera), quienes desarrollaron múltiples técnicas para identificar adecuadamente el patógeno y con ello proponer tratamientos dirigidos a la especie específica que estaba generando la enfermedad en la frutilla/fresa.
La particularidad de este hongo es que patógeno reportado no sólo en frutillas/fresas, sino también en calabaza, guisante, porotos, espárragos y ajos. Fusarium solani es capaz de sobrevivir a condiciones adversas a través de estructuras de resistencia llamadas clamidosporas. .
Clamidosporas (derecha) y Macrosporas (izquierda) producidas por Fusarium solani
La manera típica en laboratorio de identificar a los hongos de este tipo es mediante técnicas de cultivo in vitro y posterior detección de características morfológicas macro y microscópicas.
Otro mecanismo es identificando los síntomas que provocan de manera particular en la frutilla/fresa. Ambos métodos tienen la ventaja de ser relativamente sencillos, pero las grandes desventajas de requerir de un ojo experto y por supuesto tener un alto grado de error en los diagnósticos y, por ende, en las decisiones futuras de control.
Fusarium solani en medio de cultivo PDA
Es por ello que los científicos de IFAPA aplicaron la técnica molecular de PCR (Reacción en Cadena de la Polimerasa) cuantitativa ó qPCR, que se basa en la amplificación de un fragmento específico del ADN del hongo.
Aplicaron la técnica molecular a inóculo presente tanto en las plantas de frutilla/fresa como en el suelo del cultivo.
Las muestras fueron tomadas a lo largo de las campañas 2014, 2015 y 2016. Al mismo tiempo que se aplicó la técnica de qPCR se aplicó también el método tradicional de identificación mediante observación in vitro.
PCR cuantitativa o qPCR como método de detección molecular de Fusarium solani
Cabe señalar que se agregó un parámetro extra al estudio: un sector de los campos en donde se recolectaron las muestras poseía biosolarización como método alternativo de desinfección de suelo con gallinaza y otro no tenía tratamiento alguno.
Los parámetros evaluados al final del estudio fueron la densidad del inóculo de Fusarium solani, la incidencia de la enfermedad y la producción de frutilla/fresa acumulada de las plantas.
A modo de conclusiones, los científicos lograron determinar que:
- El método basado en qPCR permite una detección rápida y precisa de Fusarium solani en frutilla/fresa
- La alta precisión y especificidad del método permitirán utilizarlo tempranamente a nivel de vivero para evitar la propagación el inóculo en campo
- Mediante esta técnica se puede desplazar el método tradicional de observación in vitro, a modo de eliminar errores como falsos positivos o negativos que harían vanos los esfuerzos de control en campo
- El tratamiento de biosolarización con gallinaza podría ser una alternativa para disminuir el inóculo de Fusarium solani en el suelo, teniendo como consecuencia un impacto positivo en el rendimiento de la frutilla/fresa
Efecto el tratamiento de biosolarización en diferentes parámetros evaluados en el estudio
Te invitamos también a revisar cómo Científicos colombianos estudiaron el efecto sobre la calidad post cosecha en frutilla/fresa de 4 recubrimientos comestibles de Aloe vera y Alginato de Sodio